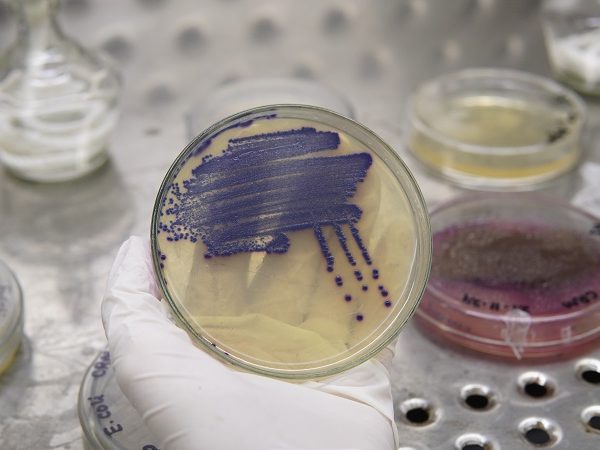
Microbiology Testing

Biotechnology & Microbiology
Testing
Ensuring food safety, maintaining quality of raw materials and finished products and meeting regulatory requirements are critical in today’s highly competitive market. BECS provides reliable and precise microbiology testing services to detect contaminants and pathogenic microorganisms in a wide range of products.
BECS state-of-the-art facilities are equipped to support diverse microbiological and biotechnology testing needs, delivering advanced solutions tailored to the unique requirements of valued clients. With a steadfast commitment to accuracy and excellence, BECS helps safeguard your products and uphold the highest standards of safety and quality.
Microbiological Testing
- TPC (Total Plate Count
- E. Coli
- Total Coliforms
- Faecal Coliforms
- Yeast and Mold
- Enterobacteriaceae
- Salmonella
- Listeria
- Shigella
- Enterococci/Faecal streptococci
- Bacillus cereus
- Compylobacter
- Pseudomonas aeruginosa
- Staphylococcus aureus
- Clostridium perfringens
- E.coli O157
- Gram Staining of Bacteria
- Endotoxin
On site sampling services

- TPC (Total Plate Count)
- E. Coli
- Total Coliforms
- Faecal Coliforms
- Yeast and Mold
- Enterobacteriaceae
- Salmonella
- Listeria
- Shigella
- Enterococci/Faecal streptococci
- Bacillus cereus
- Compylobacter
- Pseudomonas aeruginosa
- Staphylococcus aureus
- Clostridium perfringens
- E.coli O157
- Gram Staining of Bacteria
- Endotoxin
- GMO Testing
- Variety Identification
- Gene Identification
- Genome Mapping
- Marker Assisted Selection
- Allergens
- Halal Testing
- Molecular Identification of Bacteria
- Water Microbiology
- Air Bio-Burden / Environmental Microbiology
- Hygiene Monitoring (Swap sampling of contact surfaces)






